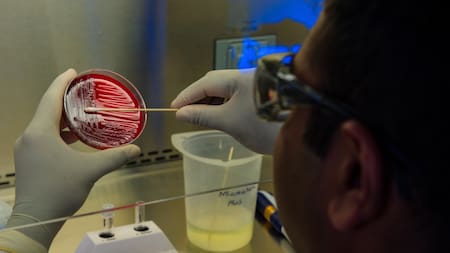
Alerta por el virus de Marburgo: qué es, cómo se contagia y por qué genera preocupación internacional

Violencia en Gaza: la OMS pospuso la nueva etapa de vacunación contra la polio por los nuevos ataques
En medio de la escalada ofensiva en el enclave palestino, la Organización Mundial de la Salud indicó que frenó el plan de vacunación y alertó de los riesgos que implica.

La situación en la Franja de Gaza es límite. En las últimas horas, la Organización Mundial de la Salud (OMS) indicó que la tercera etapa de la vacunación contra la polio en el enclave palestino fue pospuesta, producto del aumento de la violencia y el incumplimiento de las pausas humanitarias acordadas previamente.
A través de un comunicado, el organismo indicó: "Las actuales condiciones, con ataques a la infraestructura civil, siguen poniendo en riesgo la seguridad de la población y los movimientos en el norte de Gaza, lo que imposibilita a las familias el llevar a sus niños a vacunarse".

El primer niño que contrajo polio en la Franja de Gaza. Foto: Reuters.
Campaña de vacunación contra la polio interrumpida en la Franja de Gaza
Según la visión de la OMS, esta interrupción de las vacunaciones, enfocadas principalmente en las personas de menor edad, "puede poner gravemente en riesgo los esfuerzos por contener la expansión del virus de la polio en la Franja de Gaza y los países vecinos, amenazando con dejar paralizados a más niños".
En detalle, la etapa de vacunación que se frenó consistía en brindarle una segunda dosis a 119.279 niños, luego de que hayan recibido la primera a mediados de septiembre. "Muchos niños podrían perderse la segunda debido a que el área establecida para las pausas humanitarias temporales se ha reducido sensiblemente hasta abarcar sólo la capital de Gaza, mucho menos que durante la primera dosis", apunta el comunicado.
Según la agencia, al menos un 90 % de los niños de una comunidad deben ser vacunados para garantizar la efectividad de la campaña, un requisito que en las actuales condiciones no puede cumplirse. También advierte que retrasar más de seis semanas la administración de la segunda dosis de la vacuna reducirá la eficacia de la inmunización.
Un 94% del total de niños en la Franja de Gaza fueron vacunados, según los datos que acercaron desde la Organización Mundial de la Salud. En concreto, fueron 442.855 menores los que recibieron alguna dosis, tanto en el centro como en el sur del enclave.

Vacunación en Gaza contra la polio. Foto: Reuters.
En otro comunicado, la OMS también informó de la evacuación de 14 pacientes y 10 cuidadores desde el hospital Kamal Adwan, en el extremo norte de Gaza, al de Al Shifa, en la capital gazatí, también debido al aumento de las hostilidades en el área.
La misión se prolongó dos días, ya que a causa del conflicto el equipo liderado por la OMS tuvo que pasar la noche en Kamal Adwan a la espera de obtener permiso para poder cruzar la zona. En lo que va de mes, sólo 21 de las misiones solicitadas por la OMS en el norte de Gaza sólo seis han podido llevarse a cabo, destacó el comunicado.